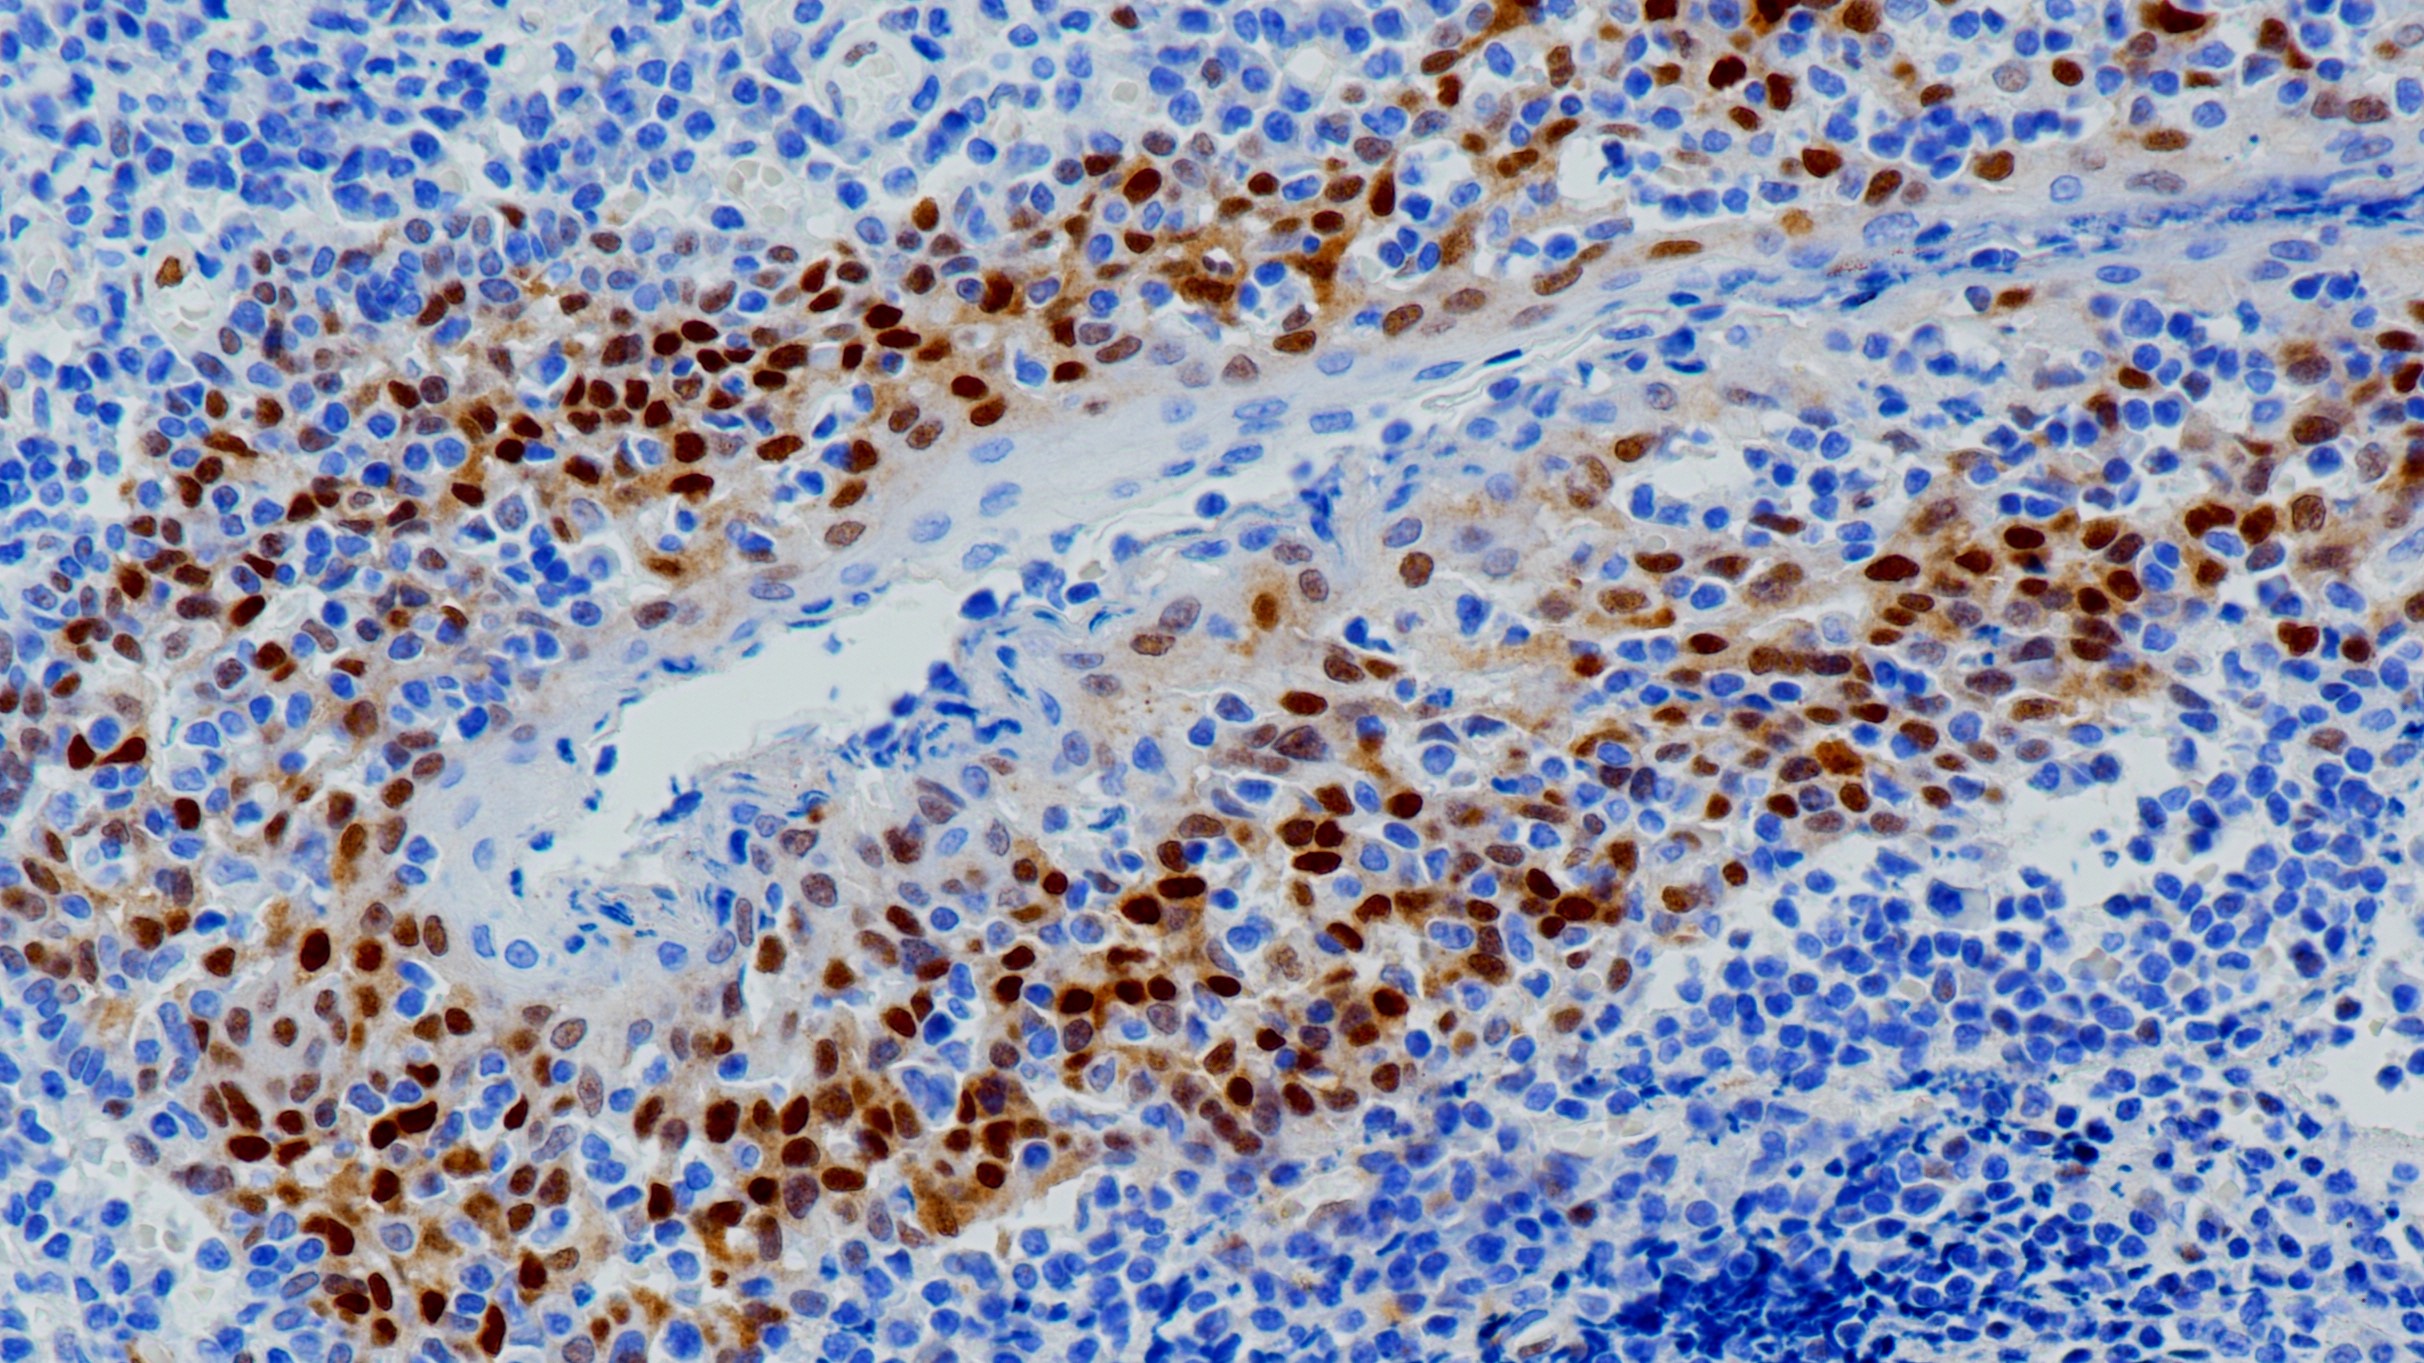
扁桃体Cyclin D1 (BP6076)染色

1. Gillett C , Fantl V , Smith R , et al. Amplification and Overexpression of Cyclin D1 in Breast Cancer Detected by Immunohistochemical Staining[J]. Cancer Research, 1994, 54(7):1812-7.
2. Fu M , Wang C , Li Z , et al. Minireview: Cyclin D1: Normal and Abnormal Functions[J]. Endocrinology, 2004, 145(12):5439-5447.
3.中华医学会.《临床技术操作规范·病理学分册》.人民军医出版社,2004.